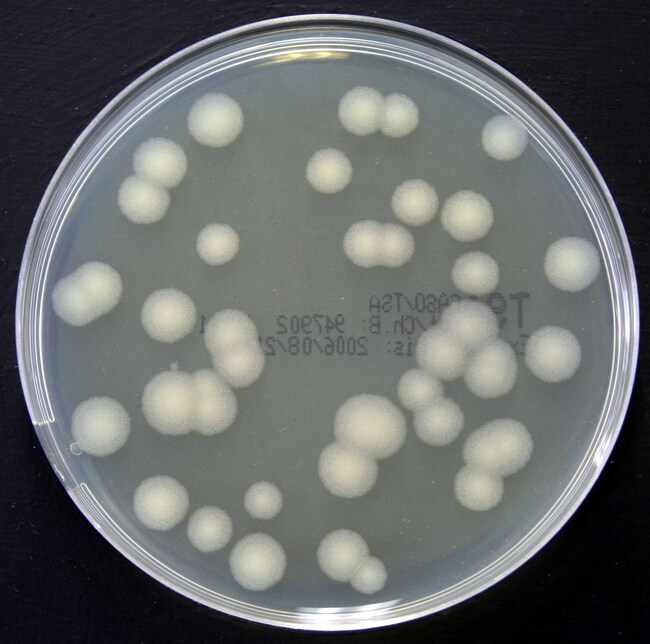
Tryptone Soya Agar Irradiated (Triple Wrap) Plate
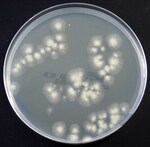
Tryptone Soya Agar Irradiated (Triple Wrap) Plate

Search
Thermo Scientific™
Tryptone Soya Agar Irradiated (Triple Wrap) Plate
Carry out environmental monitoring in the most regulated environments with this Triple Wrapped Plate for passive and active air sampling applications.
| 货号 | 产品规格 | 颜色 | 有效期 |
|---|---|---|---|
| PO0306T | 140mm Plate | 透明秸秆 | 14 Weeks |
货号 PO0306T
价格(CNY)
-
产品规格:
140mm Plate
颜色:
透明秸秆
有效期:
14 Weeks
Experience next-level cleanroom confidence with Thermo Scientific™ Oxoid™ Tryptone Soya Agar Irradiated Plate. The Tryptone Soya Agar supports the growth of wide variety of organisms.
Perform effortless environmental monitoring with Tryptone Soya Agar Irradiated (Triple Wrap) Plate.
- Sterile: plates are irradiated and triple wrapped in a transparent packaging.
- Consistent: automated manufacturing procedures ensure a smooth, evenly distributed layer of agar on each plate.
- Optimized: products undergo quantitative quality control testing, using a low dose inoculum to ensure optimum performance.
- Ready-to-use: convenience of prepared media.
Not all products are available for sale in all territories. Please inquire.
Remel™ and Oxoid™ products are now part of the Thermo Scientific brand.
规格
颜色透明秸秆
描述Tryptone Soya Agar Irradiated Triple Wrap
容纳重量88.0g – 95.0g
产品规格140mm Plate
包装类型Triple Wrapped - Irradiated
有效期14 Weeks
原料来源英国
产品类型Agar Plate
Unit SizeEach
内容与储存
2 至 25°C